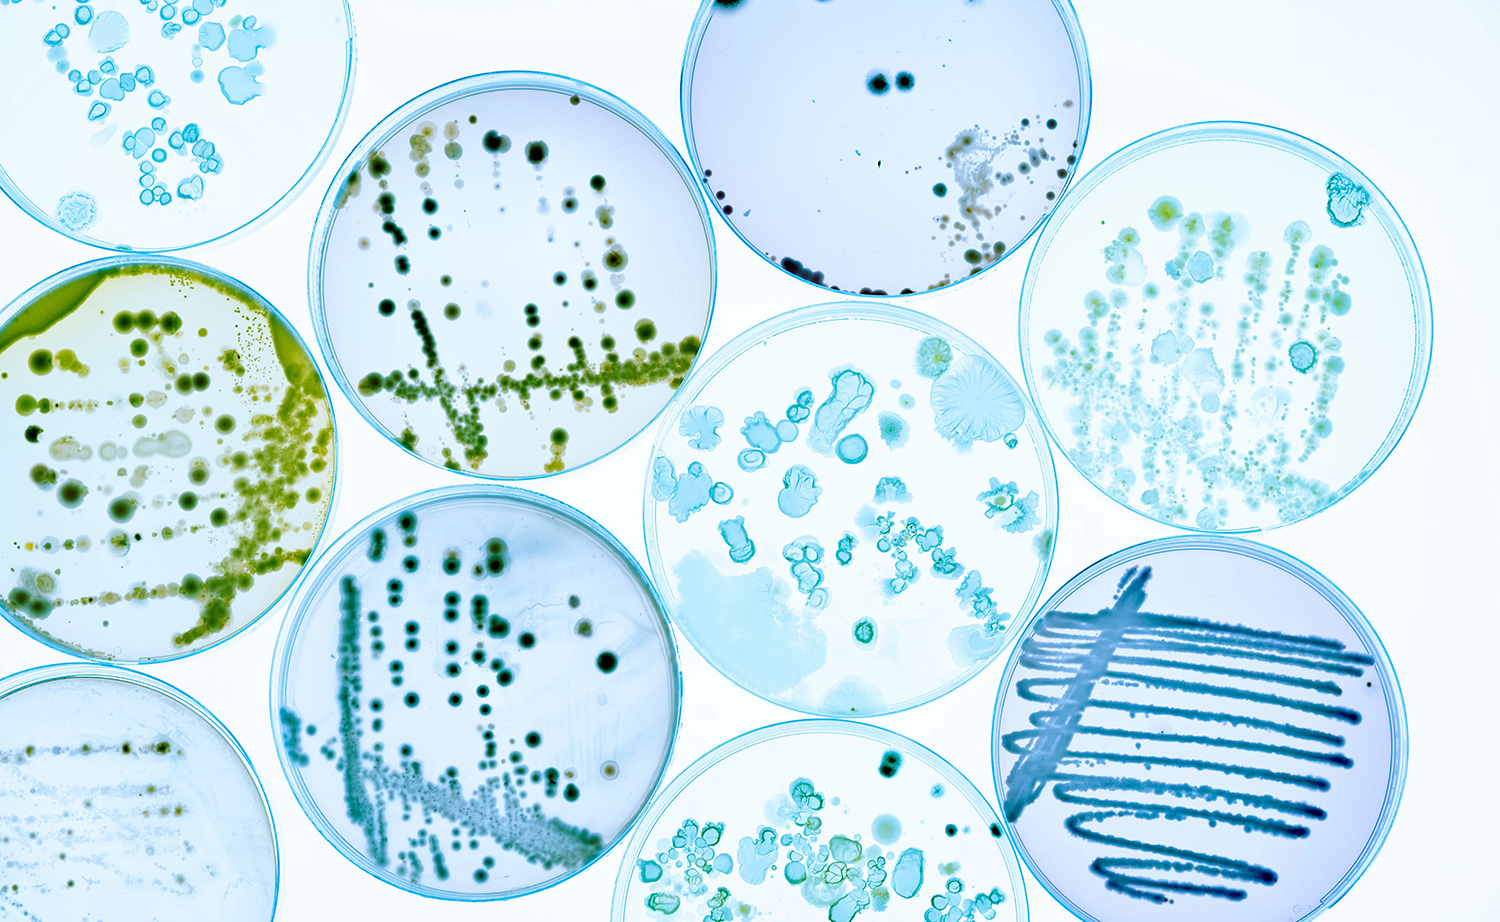

Develop an visually engaging website that highlights the research focus of the centre. Easy backend maintenance for site administrators also a prerequisite.

Our Approach
We approach website design by considering this mantra – don’t make me think. We know that even though users spend less time on websites reading content, they are familiar with the way they work. So while we aim to make our site designs fresh, the basic functionalities should still feel and work as other sites, ensuring users focus on content and not on how to use the interface.
This website was designed to highlight the CEA•STAR research through a modern and engaging interface. The interface design used brand logos and colour scheme in a cohesive and consistent way throughout the website. We custom coded the WordPress theme to suite the design interface using custom post types to make editing by the administrators straight forward and intuitive.
The theme code was then optimised for speed with minification and asymmetric loading of scripts practices employed to give the site the best chance of high native search engine ranking.
View Project
Services Delivered
